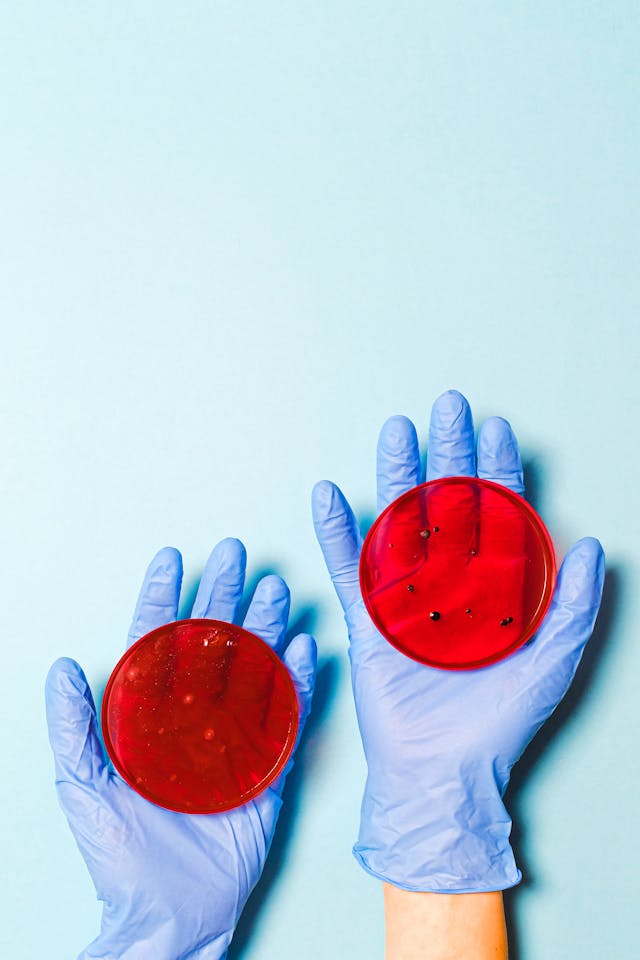
natural remedies for bv

Natural remedies for BV are essential in bacterial vaginosis disease, which is considered one of the most common vaginal diseases that occurs when the harmful bacteria (like Gardnerella vaginalis) overgrow more than the normal bacteria, mainly lactobacilli.
And when Gardnerella vaginalis increases, the result is vaginal inflammation that happens in women more than yeast infections.

Symptoms Of BV
Bacterial vaginosis BV is an Infection happens when an imbalance between good and bad bacteria occurs in the vagina, which leads to overgrowth of harmful bacteria, causing infection. The symptoms include;
- Bad odor of vagina (fishy vaginal odor)
- Itching, burning
- Unusual discharge
Risk factor of bacterial vaginosis
- Sex activities, especially when a person has more than one partner, which means that the BV is a sexually transmitted disease.
- Douching destroys the balance of bacteria in the vagina, which makes overgrowth of harmful bacteria that cause BV.

What are home remedies for BV?
Probiotics (especially lactobacillus)
- This is a good bacteria that compensates for a deficiency in good natural bacteria, which are destroyed by antibiotics.
- Microorganisms are naturally found in your digestive tract that aid in digestion and decrease inflammation.
The most common types of probiotics:
- Lactobacillus, Bifidobacterium, and saccharomyces boularidii.
- Examples of dairy products that contain probiotics (cheeses like mozzarella, kefir, buttermilk, yogurt).
Boric acid suppositories
Boric acid suppositories are antiseptics that increase the acidity of the vagina (lowering vaginal PH). This means it inhibits the growth of bad bacteria, but it can't restore good bacteria, so it is used with probiotics for the best results.
Eating yogurt
Yogurt contains lactobacilli bacteria that are also found naturally in the vagina, and eating yogurt improves the vaginal microbe and reduces B.V
Garlic supplements
Garlic contains allicin that kills harmful bacteria and reduces BV symptoms.
Apple cider vinegar
Apple cider vinegar has an antimicrobial effect, but there's no strong evidence to prove it. So you must be careful when you use it because it can irritate the vagina.
Essential food for vaginal health
Research suggests the gut plays an important role in vaginal health, so the food you eat affects vaginal health.
- The essential food for vaginal health should include fibre-rich foods such as fruits, vegetables, grains, legumes, nuts, and seeds.
- Also, eating Fructo-oligosaccharides can help intestinal health, which supports vaginal health.
- Tea tree oil
Anecdotal claims suggest that tea tree oil can help as a natural treatment. However, there's no scientific evidence.
Food you must not eat to keep your vaginal health good
Candy
Natural remedies for BV are important in women who use a lot of sugar, a lot of which is found in candy.
This promotes the secretion of the vagina with sugar, this promote growth of yeast and accumulates and alters the pH, which makes the harmful bacteria grow in it, requiring.
Alcohol
Alcohol causes dehydration of the vagina, that affect on vaginal health.
Fried food
Eating a large amount of fried food affects the balance between good and bad bacteria, which makes infection easy.
Refined carbs
Like bread increases levels of sugar in your body, and as we say, in candy, the secretion of the vagina becomes infected with sugar, which makes a good environment for yeast accumulation, and this leads to bacterial infection.
Cheese
Cheese is not like yogurt; it disturbs the good bacteria in the vagina and makes a bad odor.
Coffee
Caffeine, found in coffee, reduces our bodies' ability to fight yeast infections.
What lifestyle habits help reduce BV?
Don't forget that prevention is better than a cure!
1- Use water only for cleaning the vagina, or water with a small amount of soap.
2- Avoid douching.
3- Wear cotton and breathable underwear, and change them continuously.
4- Make Good Hygiene (using Wipes from front to back after using the toilet to prevent the spread of bacteria from rectum to vagina).
5- Drink lots of water that make you vagina hydrated and healthy.
6- Eat yogurt and garlic supplements, which increase probiotics.
7- Eat healthy food like fruit, vegetables, and grains.
8 -Avoid unhealthy food like sugar, candy, and fried food.
What are the differences between bacterial vaginosis and yeast infection?
- In bacterial vaginosis, there is thin, white or grey discharge, but in east infection, the discharge is thick and white with a cheesy consistency
- In bacterial vaginosis, the odor of the vagina is fishy, but in yeast infection, there's no odor in the vagina.
- In yeast infection, there is inflammation and redness of the vulva, but in BV, it is not found.
-Finally, itching is found in two types.
How do we avoid transferring BV from a woman to her partner?
Natural remedies for BV or antibiotics used to treat infection in women, or the two together, using a condom during sex to avoid direct touching
Couples should avoid sexual intercourse until the woman is treated for the infection.
Are home remedies for BV effective without antibiotics?
Natural remedies for bv used in mild infections without antibiotics because antibiotics not only kill bad and harmful bacteria but also it kills good bacteria, and use it more and more leads to bacterial resistance
which means if you use these antibiotics for disease treatment, it will not give you a result, so natural remedies for BV are good for mild cases, but when the infection is severe, antibiotics are essential, and according to the CDC (Centers for Disease Control and Prevention) the first line of care is antibiotics but natural remedies for BV can manage the recurrent BV
Some antibiotics are used to treat severe cases of bacterial vaginosis, with natural remedies for BV
- Metronidazole (Flagyl)
- Tinidazole (Tindamax)
- Clindamycin (Cleocin)
When do you see your doctor?
Natural remedies for BV are used for treatment, but they do not give the desired result.
If symptoms of BV (itching, burning, and bad odor) remain or even increase, you should go to a doctor to solve your problem by diagnosing your case correctly and determining if you suffer from BV or a yeast infection, and give you appropriate drugs in addition to natural remedies for BV.
What happens if BV is not treated?
If natural remedies for BV or antibiotics are not used to treat the infection, it can cause pelvic inflammatory disease
increase infections that are sexually transmitted.
Summary
Natural remedies for BV are used to treat and reduce the symptoms, and reduce bacterial resistance that has developed from using antibiotics more and more often.
- Drink more and more water.
- Eat healthy food and avoid fast food and unhealthy food.
- If your condition is severe, you should see a doctor and use natural remedies for BV with antibiotics to get the best result.
And you always remember that the hygiene of the vagina is with water only or water with a little amount of soap.
- Wearing breathable cotton underwear and changing it continuously is essential to reduce BV.
You must be logged in to post a comment.